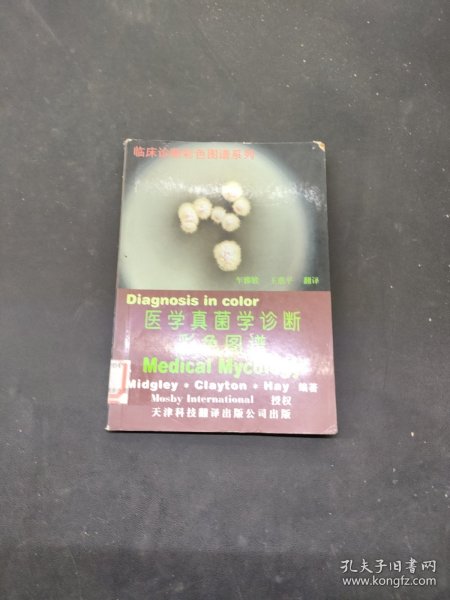
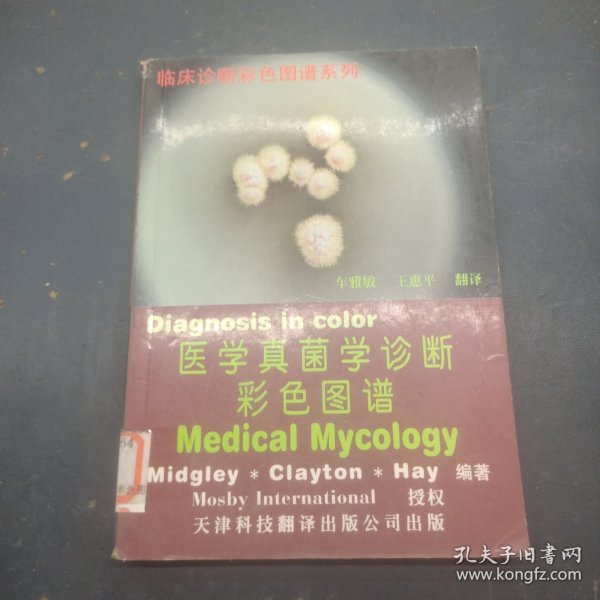
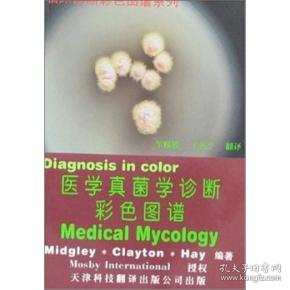
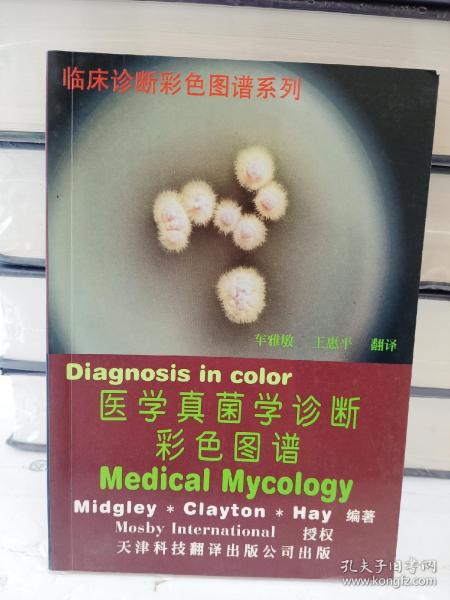
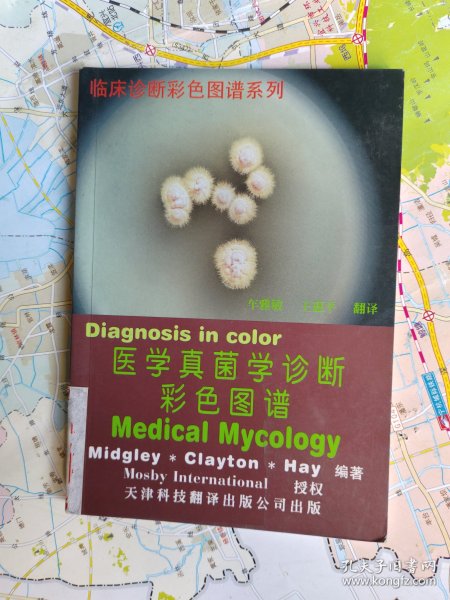
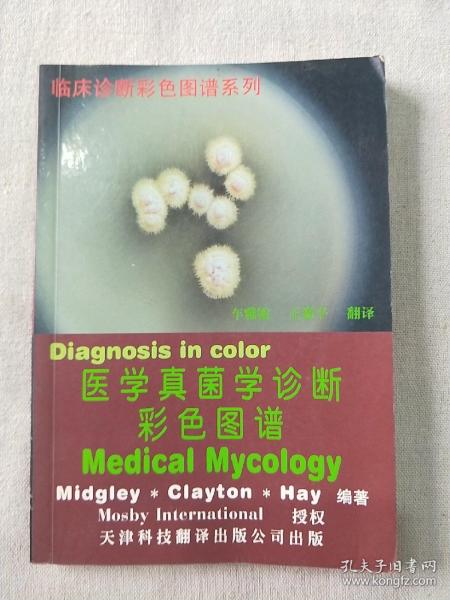
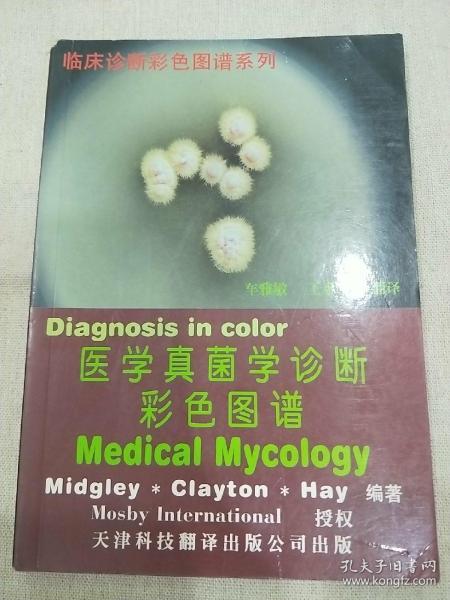
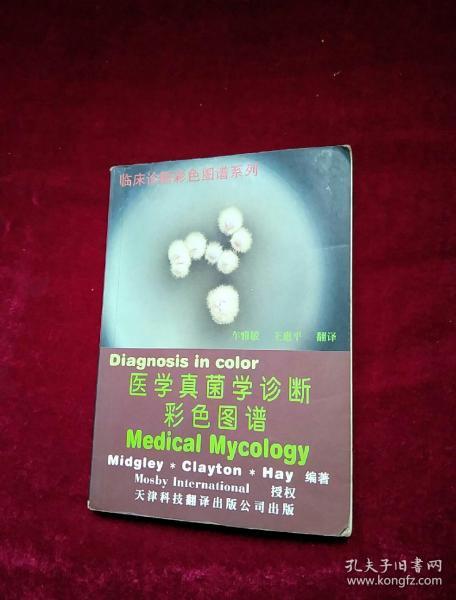
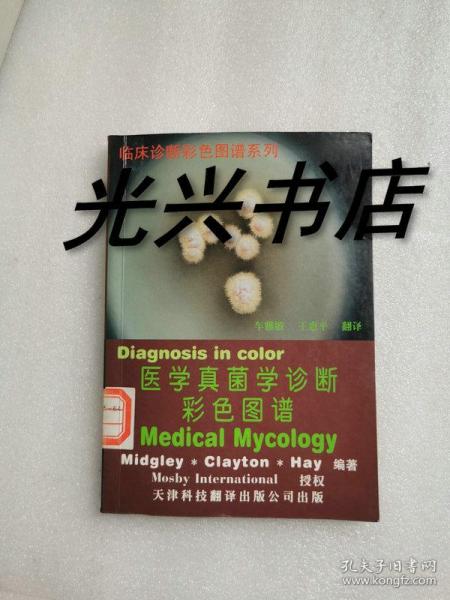

客服电话
010-89648155
服务时间
客服咨询 08:00-21:00
纠纷处理
09:00-12:30
13:30-18:00
图书审核 09:00-18:00

 占位居中
占位居中